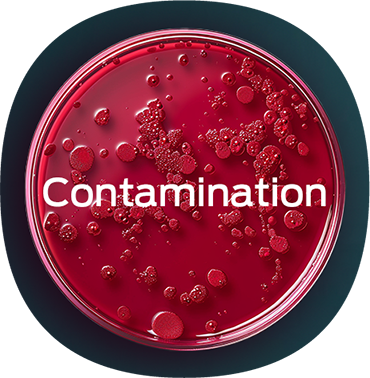

Contamination? Power Outage? Not your problem anymore! Keep your cells protected in difficult environment.
What Challenges Do Your Cells Face?
- Searching for a solution to contamination by bacteria, yeasts, and other organisms that could adversely affect your valuable cell cultures?

- Or concerned about the potential impact of a power failure on sensitive cultures, particularly in uncontrolled temperature and environmental conditions?
... be Ready To Safe Your Cells If Needed

- Use the portable incubator for protection: Effectively isolate contaminated cell cultures.
- Use the portable incubator for protection: Effectively isolate contaminated cell cultures.

- Get the backup power supply: Protect your cell lines from unexpected power failures with our included battery system.

- Get active temperature and CO₂ monitoring: Early warning systems detect deviations from optimal conditions.

CELLBOX™ GO
The portable CO2 incubator for short and mid distance transports - smart and easy to carry: Now available

CELLBOX™ SHIPPER
The portable CO2 incubator for Long distance transports - up to 48 hours runtime.
A Recent Use Case
In their groundbreaking research on Plasmodium falciparum gametocytogenesis, our customer SciLifeLab utilized with the University of Stockholm cutting-edge single-cell RNA sequencing to explore the transcriptional programs of male and female gametocytes. To ensure the integrity of these sensitive samples and minimize the risk of contamination, they employed a portable incubator.
This allowed for the safe transport and on site inucbation of the samples under constant, controlled conditions, which was crucial for such complex and time-sensitive experiments. The use of the Cellbox™ technology played a vital role in the precision and reliability of their findings.



Early warning systems for timely reactions.

No interruptions thanks to emergency power supply.

Want To Learn more?
Want To Learn more?
Get in Touch
Senior Director Business Development & Sales

